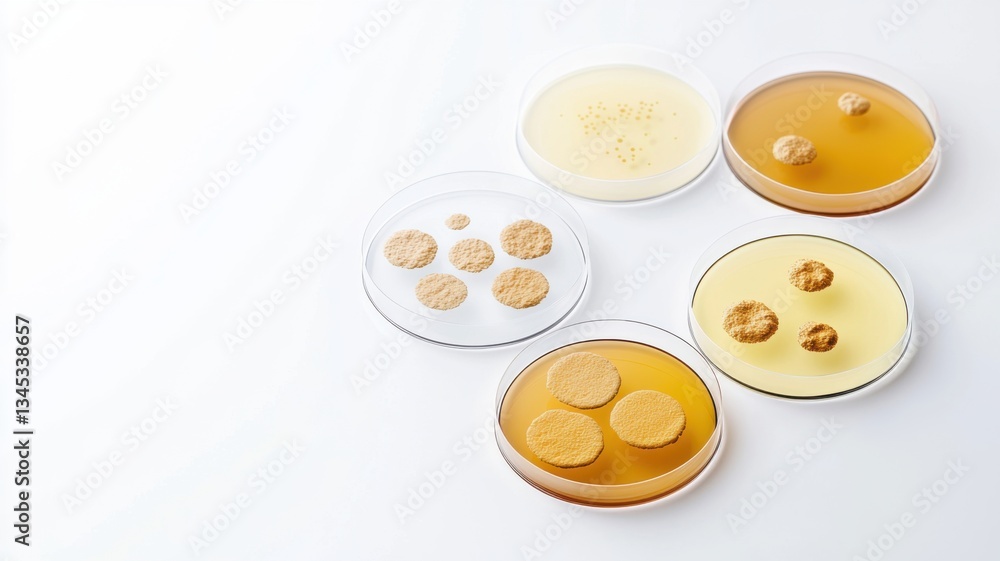
Obraz premium Petri dishes containing different cultures of bacteria, showcasing various growth patterns and colors on a clean surface.

RABAT DO 40% - wygasa 08.03 !!! | Darmowa dostawa od 290zł | Potrzebujesz pomocy? Zadzwoń 22 678 07 67
Użyj wyszukiwarki i szukaj wśród milionów zdjęć.
OBRAZ
Główne cechy:
• wysyłka od 390 zł gratis • jakość PREMIUM • atest PZH • trwałe ramy wykonane z MDF • idealny na prezent • dowolny rozmiar • wydruk na canvasie - bawełnianym materiale o strukturze płótna - wyglądającym jak płótno malarskie zabezpieczenie wydruku laminatem płynnym, czyli werniksowanie • kolory utrzymują wybarwienie przez ponad 10 lat • Eco Friendly - pracujemy na produktach przyjaznych środowisku
Zastosowanie:
• każde pomieszczenie, czyli salon, sypialnia, kuchnia, łazienka, przedpokój, pokój dziecięcy, hotel, restauracja, sala konferencyjna, budynki użytku publicznego, szkoły, przedszkola, żłobki.
Klient otrzymuje od nas gotowy produkt do powieszenia na ścianie.
UWAGA
dodatkowa ramka, którą widzisz wokół kadru grafiki to część materiału canvas, jaki zachodzi na boki Twojego obrazu, czyli grafika jest kontynuowana, poza główną powierzchnią także na bocznych płaszczyznach obrazu.